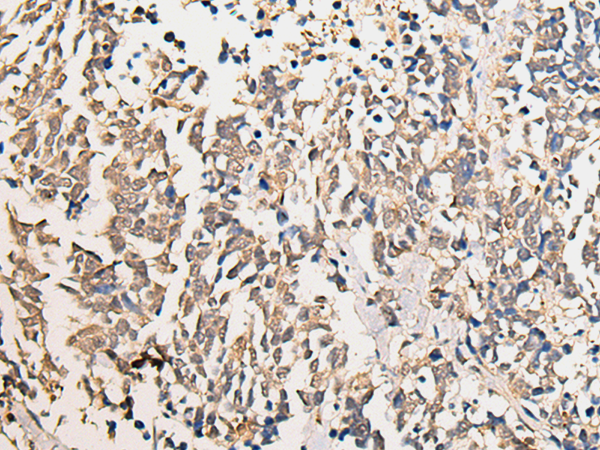

|
Background: |
The CHD family of proteins is characterized by the presence of chromo (chromatin organization modifier) domains and SNF2-related helicase/ATPase domains. CHD genes alter gene expression possibly by modification of chromatin structure thus altering access of the transcriptional apparatus to its chromosomal DNA template. Alternatively spliced transcript variants encoding distinct isoforms have been found for this gene. |
|
Applications: |
ELISA, IHC |
|
Name of antibody: |
CHD2 |
|
Immunogen: |
Fusion protein of human CHD2 |
|
Full name: |
chromodomain helicase DNA binding protein 2 |
|
Synonyms: |
EEOC |
|
SwissProt: |
O14647 |
|
ELISA Recommended dilution: |
5000-10000 |
|
IHC positive control: |
Human lung cancer |
|
IHC Recommend dilution: |
25-100 |
購物車
購物車 幫助
幫助
 021-54845833/15800441009
021-54845833/15800441009
